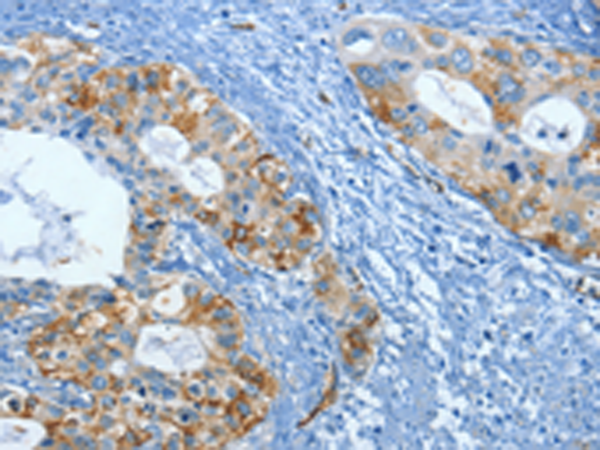
一抗

|
Background: |
This gene encodes a member of the fascin family of actin-binding proteins. Fascin proteins organize F-actin into parallel bundles, and are required for the formation of actin-based cellular protrusions. The encoded protein plays a critical role in cell migration, motility, adhesion and cellular interactions. Expression of this gene is known to be regulated by several microRNAs, and overexpression of this gene may play a role in the metastasis of multiple types of cancer by increasing cell motility. Expression of this gene is also a marker for Reed-Sternberg cells in Hodgkin's lymphoma. A pseudogene of this gene is located on the long arm of chromosome 15. |
|
Applications: |
ELISA, IHC |
|
Name of antibody: |
FSCN1 |
|
Immunogen: |
Fusion protein of human FSCN1 |
|
Full name: |
fascin actin-bundling protein 1 |
|
Synonyms: |
HSN; SNL; p55; FAN1 |
|
SwissProt: |
Q16658 |
|
ELISA Recommended dilution: |
2000-5000 |
|
IHC positive control: |
Human cervical cancer and Human ovarian cancer |
|
IHC Recommend dilution: |
25-100 |

 購物車
購物車 幫助
幫助
 021-54845833/15800441009
021-54845833/15800441009